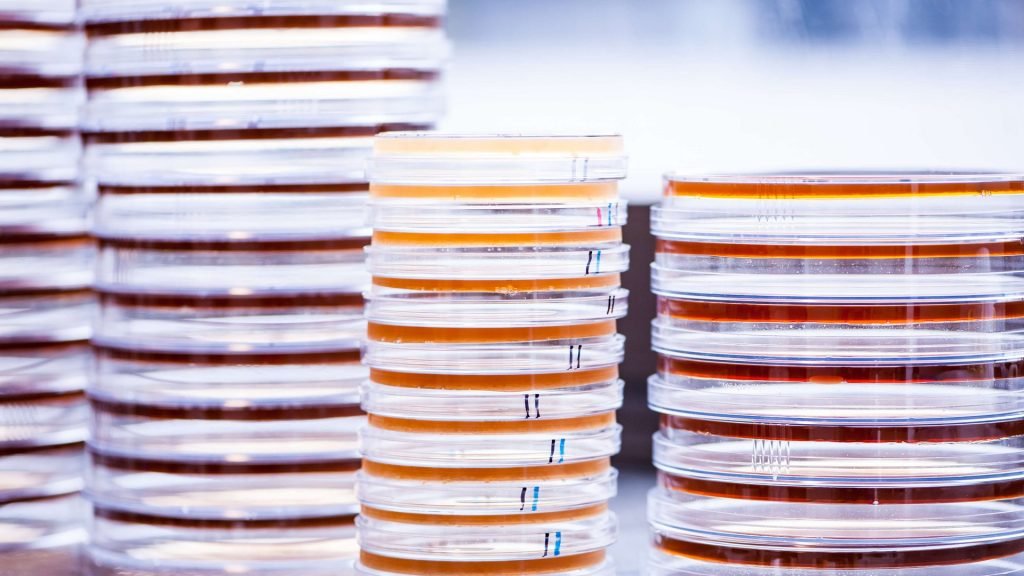

In the past ten years, there has been a significant increase in cases where drugs and injections containing antibiotics have been recalled by FDA. The very simple reason to justify the steps of FDA is fungal and microbial contamination. The risk associated with contamination in antibiotic injectable is so high that it can put the patient’s life on stake. Maintenance of sterility at pharma plants has ever since been highly prioritized. Regular sterility check tests must be conducted to monitor the contamination that might exist in the plant’s manufacturing environment. But due to high susceptibility of antibiotic presence in the samples taken from such environment, usually the tests give a false negative result for contamination. The antimicrobial activity of the antibiotic interferes with the test and represses the growth of the contaminant. Thereby giving a negative result, which is a false indeed as a negative result doesn’t imply the complete eradication of the contaminants from the sample. Therefore, the inability of the test to promote the growth of the contaminants renders a false result.
This problem can be easily solved if an agent could be used to nullify the antimicrobial activity of the antibiotic present in the sample. In that case, the contaminants would be free to grow, and their proliferated colonies could be easily visualized to test for the sterility of the plant’s environmental sample. Through billions of years of bacterial evolution, it has been noticed that some gram-negative bacteria have evolved to be resistant to β-lactam antibiotics. In an environment containing antibiotics, these bacteria secrete an enzyme called beta-lactamase. All β-lactam antibiotics are essential chemical derivatives of a beta lactam ring which is precisely a four-atom constituted ring and adopt a specific pathway to cell’s destruction.
The Beta-lactam antibiotics- mechanism of action
In the bacterial cell, there are present some special proteins called Penicillin Binding proteins (PBP). These play an immensely important role at the terminal stage of cell wall biosynthesis but are highly susceptible to the activity of beta-lactam antibiotics. PBPs carry a sensitive activated serine site which gets acylated due to the action of beta lactam antibiotics.
Once acylated, PBP is bound covalently by an acyl bond to the beta lactam antibiotic molecule. But subsequently, deacylation takes place and the complex is relived of the active PBP, leaving a hydrolyzed, inactive, ring-opened beta lactam antibiotic molecule behind. Since the rate of deacylation is very slow in this case, much slower than the lifetime of the cell, the cell wall breaks down in absence of active PBP enzyme and the cell eventually dies away.

Counter control with Beta-lactamase plates
β lactamases share a huge extent of similarity with PBPs. The similarity and genetic homology are so high that it is popularly assumed that beta lactamases have evolved from PBP. Like PBP, beta lactamases also carry an activated serine site, but they exhibit a higher rate of deacylation than PBP enzyme, thus making a PBP like protein molecule readily available for cell wall biosynthesis without compromising with the cell’s life period. This changes the dynamics of the enzymatic process which governs the inactivation of beta lactam antibiotics and successfully deactivates the antibiotic molecules without causing any danger to the cell wall. Penicillin is an example of a beta-lactam antibiotic which is deactivated by penicillinase, a beta-lactamase enzyme.
In recent years, beta lactamases have found huge applicability in sterility checks as beta lactamase plates. These plates contain the usual growth promoting nutrients along with some amounts of beta lactamase enzyme depending on the concentration of the antibiotic that might be present in the sample. Such plates are generally used for sterility tests where the sample is suspected to contain antibiotics which might give a false negative result. The antibiotic compound present in the sample is taken as substrate by the beta lactamase enzyme present in the plate, which gets rid of the antimicrobial activity of the antibiotic. The growth of contaminants afterwards is the true result to confirm the contamination in the sample without any dominant effect from the antibiotic.
According to USP chapter 71, it is now mandatory to add beta lactamase to test the sterility of media containing penicillin or cephalosporin antibiotics. A huge risk to human life is incorporated with contamination at facilities where antibiotics are either being manufactured or used to manufacture drugs. Past incidents suggest that patients can experience hypoxia and can become hypotensive, and unresponsive with seizure activity, within one hour after administering vancomycin injection contaminated with Burkholderia cepacia. Thus, being extra sure by conducting true sterility tests using beta lactamase plates becomes quite essential as a protocol in today’s pharma
In every microbiology laboratory, there are situations where selective isolation becomes critical. A specimen is received with a suspicion of...
Read More
In microbiology laboratories, there are moments when identifying enteric bacteria becomes critical. A sample may contain a mix of organisms,...
Read More
In microbiology, good results depend not only upon the techniques used in the laboratory, but also on the state of...
Read More
Imagine being able to grow thousands of identical, healthy plants from one parent plant, all alike in quality, vigor, and...
Read More
In microbiology, not all bacteria can be cultured in the same environment. Their requirements are different, some need oxygen to...
Read More
Every microbiology laboratory has times when accuracy is more important than anything else. A urine sample arrives with a suspicion...
Read More